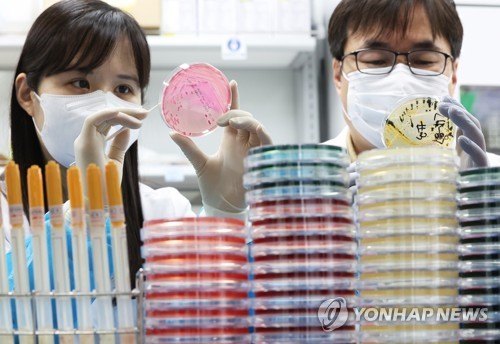

티스토리 뷰
목차
충청권 군부대 식중독 비상: 대전 군수지원단 납품 식자재 '역학 조사' 돌입, 장병 190여 명 설사·구토 증세
목차
최근 충청권 일대 군부대 여러 곳에서 식중독 의심 환자가 동시다발적으로 발생하여 보건당국이 긴급 역학 조사에 착수했습니다. 충북 지역 13개 부대에서만 장병 140여 명이, 충남·대전·세종 지역에서도 50여 명의 장병이 설사, 구토 등의 증세를 호소하며 치료를 받은 것으로 파악되었습니다. 이들 부대에 공통적으로 대전 소재 군수지원단이 식자재를 납품한 사실이 확인되면서, 납품된 식자재가 대규모 식중독 사태의 원인이 되었을 가능성에 무게가 실리고 있습니다.
1. 충청권 군부대 다발성 식중독 의심 환자 발생 현황
식중독 의심 증세는 장병들이 전날 저녁 식사를 마친 뒤 발생하기 시작했습니다. 충북도에 따르면, 3일 오후 4시 기준으로 청주와 보은 등을 포함한 도내 9개 시·군 13개 부대에서 약 140여 명의 장병이 설사와 구토를 주 증상으로 호소했습니다. 다행히 대부분은 신속히 병원 치료를 받고 상태가 호전된 것으로 알려졌습니다.
이와 함께, 충남 보령, 태안, 대전, 세종 등 충청권 타 지역의 군부대에서도 50여 명의 장병이 유사한 식중독 의심 증세를 보인 것으로 확인되어, 총 190여 명에 달하는 장병이 동시에 건강 이상을 겪는 대규모 사태로 번졌습니다. 군 관계자는 추가 증상 호소자가 소규모 부대별로 더 있는 것으로 파악되지만, 정확한 수치 파악이 어려운 상황이라고 덧붙였습니다.
2. '대전 군수지원단'발(發) 식자재 공동 납품 경로 확인
보건당국은 광범위한 지역의 군부대에서 동시다발적으로 식중독 의심 환자가 발생한 원인을 추적하는 과정에서 공동의 경로를 발견했습니다. 환자가 발생한 이들 군부대 전체에 전날 대전 소재의 군수지원단이 식자재를 납품한 사실이 확인된 것입니다.
해당 군수지원단은 충청권 모든 지역 군부대의 식자재 일괄 구매와 처리 등을 담당하는 중앙 허브 역할을 하고 있습니다. 다만, 식자재의 실제 배송 과정은 민간업체에 위탁하여 진행된 것으로 알려져, 식자재 자체의 문제인지, 혹은 배송 및 보관 과정에서의 변질이나 오염 문제인지에 대한 정밀한 조사가 필요할 것으로 보입니다.
3. 민관 합동 역학 조사 착수: 원인 규명에 총력
대규모 식중독 의심 사태의 심각성을 인지한 보건당국과 군 당국은 즉시 민관 합동 역학 조사에 착수했습니다. 충북도 관계자는 "일선 시군 보건소가 군부대와 접촉해 역학 조사를 벌이고 있다"고 밝혔습니다. 군 당국 역시 부대별로 식자재, 배송 과정, 식수 상태 등을 다각도로 확인하며 원인 추적에 힘을 쏟고 있습니다.
현재 가장 중요한 단계는 정확한 검체 분석입니다. 군 관계자는 "원인 역시 역학조사를 해봐야 알 것 같다"며, 환자들의 시료를 채취해 보건당국에 검사를 의뢰할 예정임을 밝혔습니다. 이 검체 분석 결과가 나와야만 식중독을 유발한 정확한 감염 경로와 원인균을 판단할 수 있기 때문입니다.
4. 군 당국의 초기 대응 및 추가 환자 파악 어려움
식중독 증상을 호소하는 장병들은 저녁 식사 후 증세를 보여 즉각적인 치료를 받았으며, 대부분 호전된 상태입니다. 그러나 군 당국은 추가적인 증상 호소자가 계속 나오고 있음에도 불구하고, 예하 부대별로 소규모로 발생하는 경우가 많아 정확한 수치 파악에 어려움을 겪고 있다고 토로했습니다.
이는 군부대라는 특수성으로 인해 외부 보건당국과의 즉각적인 정보 공유 및 환자 집계에 시간이 소요될 수 있음을 시사합니다. 군 당국은 상황 파악과 함께, 장병들의 건강 상태를 면밀히 모니터링하고 추가적인 피해 확산을 막는 데 주력해야 할 것입니다.
5. 검체 분석 결과 예고와 향후 후속 조치 계획
보건당국은 역학 조사를 통해 수집된 검체를 분석하는 데 상당한 시간이 소요될 것으로 예상하고 있습니다. 충북도 관계자는 "검체 분석 결과는 2주 뒤에 나올 예정"이라며, "조사 결과를 바탕으로 정확한 감염 경로를 판단할 계획"이라고 설명했습니다.
식중독균의 종류와 오염 경로가 명확히 밝혀지는 대로, 보건당국과 군 당국은 원인을 제공한 식자재 공급처나 배송 업체에 대한 행정 조치 및 책임 추궁 등 후속 조치를 단행할 방침입니다. 장병들의 건강과 직결되는 문제인 만큼, 군부대 식자재 공급 시스템 전반에 대한 철저한 점검과 개선이 뒤따라야 할 것입니다.